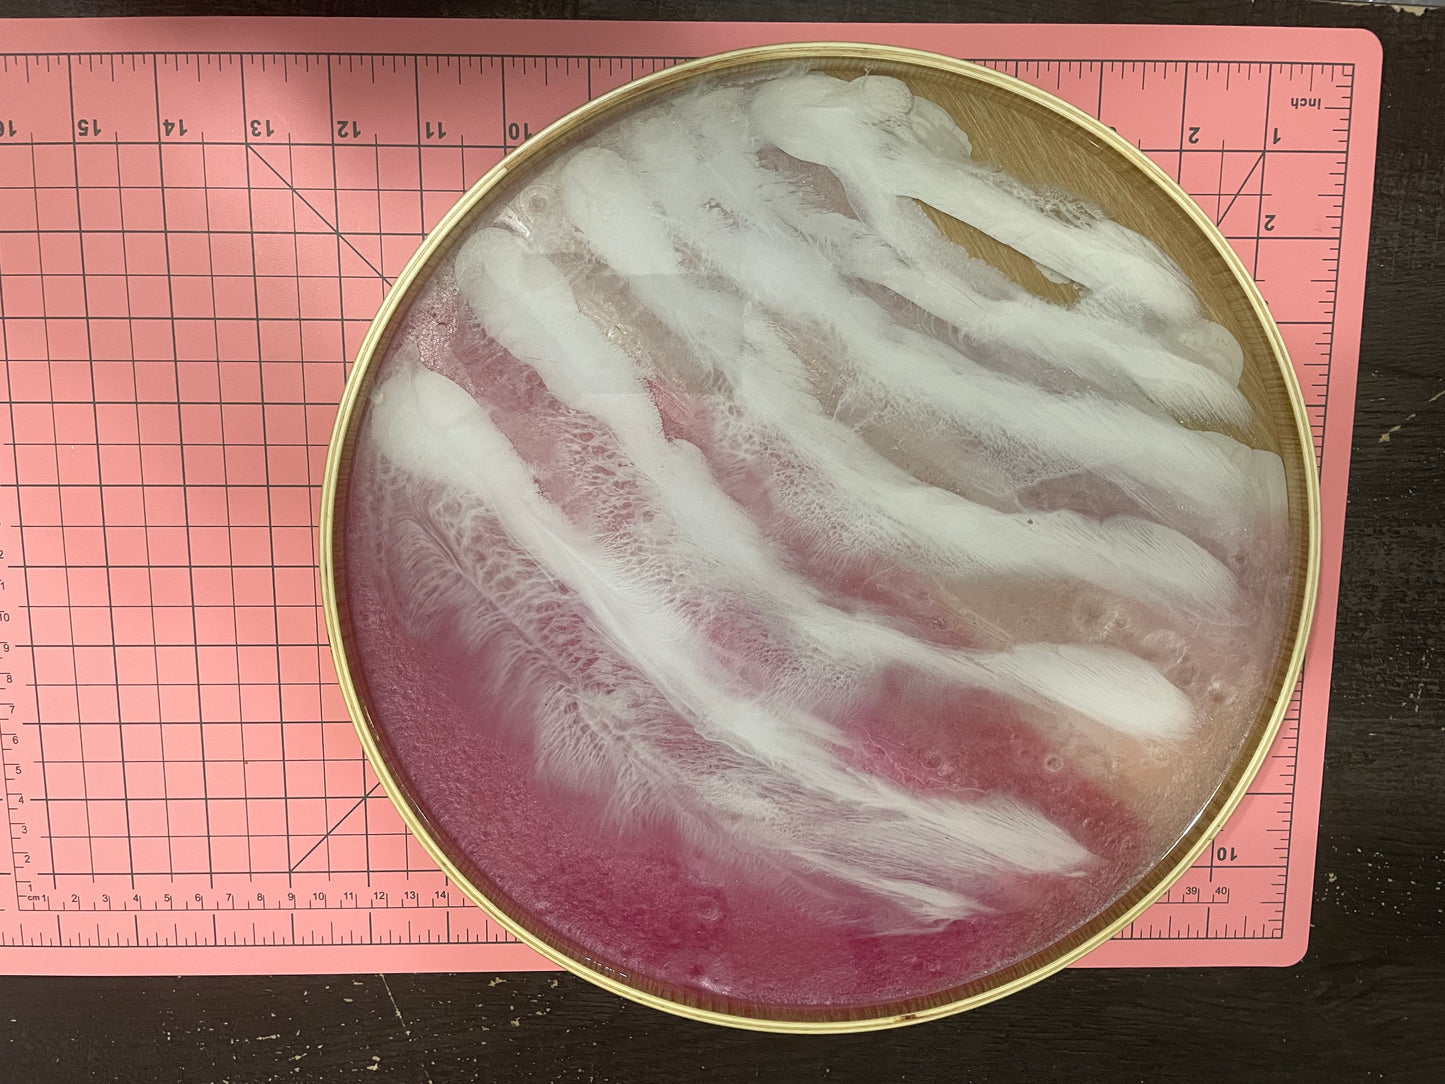

Wall Decoration
-
Wolf Head :Resin Wall Art
Regular price $50.00 CADRegular priceSale price $50.00 CAD -
Horse Duo Wall Decoration
Regular price $30.00 CADRegular priceSale price $30.00 CAD -
Elephant Wall Decoration
Regular price $30.00 CADRegular priceSale price $30.00 CAD -
Handcrafted Resin Guitar Wall Hook – with Real Dried Flowers
Regular price $35.00 CADRegular priceSale price $35.00 CAD
Keychains
-
Ocean Whale Glass Cabochon Keychain
Regular price $8.00 CADRegular priceSale price $8.00 CAD -
Dolphin Keychain
Regular price $6.00 CADRegular priceSale price $6.00 CAD -
Dried Flower Cat Keychain
Regular price $8.00 CADRegular priceSale price $8.00 CAD -
Butterfly keychain
Regular price $6.00 CADRegular priceSale price $6.00 CAD
Jessie Petite Boutique
Pink Ocean-Round Wood and Resin Tray – Unique Handmade Art Piece
Regular price
$80.00 CAD
Regular price
Sale price
$80.00 CAD
Shipping calculated at checkout.
Quantity
Jessie Petite Boutique
Long Wooden Steampunk Tray
Regular price
$38.00 CAD
Regular price
Sale price
$38.00 CAD
Shipping calculated at checkout.
Quantity

Collections
-
Handmade Eco Resin Candles
Discover the soothing glow of our handcrafted candles — 100% made by...
Other items
-
Hexagon Eco-Resin Ring Holder
Regular price $5.00 CADRegular priceSale price $5.00 CAD -
Heart-Shaped Eco-Resin Card Holder
Regular price $10.00 CADRegular priceSale price $10.00 CAD -
Cat + Dog Resin Figurines
Regular price $10.00 CADRegular priceSale price $10.00 CAD -
Girl and Dog Figurine Set
Regular price $15.00 CADRegular priceSale price $15.00 CAD -
Flower-Shaped Wooden Coasters with Glow-in-the-Dark Pink Resin (Set of 5)
Regular price $30.00 CADRegular priceSale price $30.00 CAD -
Ocean Eco Resin Coaster Set with Cork Base (Set of 4)
Regular price $30.00 CADRegular priceSale price $30.00 CAD -
Wooden Coaster Set with Dried Flowers and Resin Finish (Set of 4)
Regular price $30.00 CADRegular priceSale price $30.00 CAD -
Eco Resin Coaster Set with Pansy Flowers (Set of 4)
Regular price $30.00 CADRegular priceSale price $30.00 CAD -
Elephant Resin Bank
Regular price $25.00 CADRegular priceSale price $25.00 CAD -
Resin Dog Puzzle – 7 Pieces
Regular price $20.00 CADRegular priceSale price $20.00 CAD -
Sparkly Resin Pig Figurine
Regular price $15.00 CADRegular priceSale price $15.00 CAD -
White Eco-Resin Candle Holder
Regular price $10.00 CADRegular priceSale price $10.00 CAD -
Red Eco-Resin Candle – Clean Lemon Soy Wax
Regular price $30.00 CADRegular priceSale price $30.00 CAD -
Black Planet Candle – Clean Lemon Soy Wax
Regular price $30.00 CADRegular priceSale price $30.00 CAD -
Blue Eco-Resin Candle – Forest of Firs Soy Wax
Regular price $16.00 CADRegular priceSale price $16.00 CAD -
Grey Eco-Resin Candle – Clean Lemon Soy Wax
Regular price $18.00 CADRegular priceSale price $18.00 CAD
Jessie Petite Boutique
dried flowers on small oval wooden tray
Regular price
$25.00 CAD
Regular price
Sale price
$25.00 CAD
Shipping calculated at checkout.
Quantity

You would like something special, one of a kind, a keepsake, or a memory piece. Thats what we do!
Just contact me with the contact form bellow and let's see what we can create together!